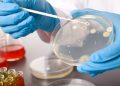
Трихомониаз оорусун канча убакытта дарыласа болот? Уролог жооп берет

Жыныс мүчөнүн ичин жуушу керекпи же жокпу? Айымдар үчүн тест
Bilesinbi.kg 28-май менстуралдык гигиена күнүнө карата айымдар үчүн тест түздү. Өзүңүздү бир сынап көрүңүз. Эже-сиңдилериңизге же курбуларыңызга бөлүшкөндү унутпаңыз. Бул жерден ...
Толук окууDetails